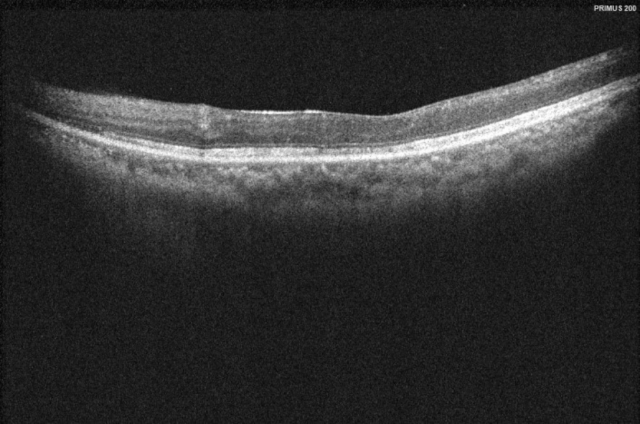

随着高考的临近,不少家长为考生的饮食营养操碎了心,甚至有家长试图通过各种营养补充剂或保健品为孩子的高考“加分”。广州市第一人民医院营养科副主任医师沈峰提醒,均衡饮食才是关键。若考生通过日常饮食能获得所需营养,就没有必要服用补充剂或保健品;若考生有特殊的营养需求或缺乏某种营养素,可在医生的指导下适当补充,比如用眼过多的考生可以补充叶黄素等。高考进入倒计时,学生在教室复习。南方+记者 朱洪波 摄如何实现均衡饮食?...
阅读次数:2024-06-07“2016年我们医院产科分娩量出现高峰,随后逐渐呈下降趋势。产科的床位数减少,人员也分流了一个小组。”近日,广州市第一人民医院产科主任程杨接受羊城晚报记者采访时如是谈道。产科萎缩,这是当前不少医院共同的无奈。在暨南大学附属第一医院,产科已连续几年未进新人。明天是一年一度的母亲节。诚然,对于准妈妈们而言,产科床位远比以往充裕,七八名医生护士围着一位产妇转,她们被悉心照护,享受着VIP待遇;但对于产科医务人员来说,...
阅读次数:2024-05-28 《南方日报》护士节“邂逅”母亲节,她们的双重身份藏不住了
《南方日报》护士节“邂逅”母亲节,她们的双重身份藏不住了
在漫长的一生中,女性有很多角色,是女儿,是妻子,是母亲……当你身在襁褓,有人守护你健康成长,她的名字叫母亲;当你卧病在床,有人帮助你早日康复,她的名字叫护士。5月12日是第113个国际护士节,也是母亲节,当护士节“邂逅”母亲节,对既是母亲又是临床一线的护士来说,这个日子有了双重意义。在这个特殊的节日,南方+记者走进广州三家医院的新生儿重症监护室、老年医学科和精神科,探究“护士妈妈”们精力旺盛、为母则刚的背后,...
阅读次数:2024-05-16一头飘逸、乌黑的秀发,谁不想拥有呢?《木兰辞》中写道,“当窗理云鬓,对镜贴花黄”,美丽的头发更显女子容貌昳丽。但15岁的小美(化名)却对薅自己的头发很上瘾,甚至快把自己拔秃了。专家表示,这是典型的拔毛症,而这背后通常隐藏着心理问题。少女把自己头发拔秃了两周前,15岁的小美(化名)在爸爸陪伴下走进了广州市第一人民医院的心理科诊间,爸爸说小美爱拔头发,甚至快把自己拔秃了。说罢提起原本还覆盖着头顶的“齐肩假发”...
阅读次数:2024-04-29 《新华社》广州发布首个幽门螺杆菌抗生素耐药报告
《新华社》广州发布首个幽门螺杆菌抗生素耐药报告
新华社客户端广州4月11日电(徐弘毅 蔡文轩)《广州幽门螺杆菌抗生素耐药监测报告及根除治疗建议(2024)》10日发布,该报告由广州市第一人民医院、广州地区消化疾病质控中心、广州市医师协会、广州市医学会联合发布,旨在为临床医生提供切实可行的诊治策略,为幽门螺杆菌防治工作提供有益参考。幽门螺杆菌(Hp)作为常见的消化道致病菌,其耐药性问题一直是医学界关注的焦点。该报告主发布人、广州市第一人民医院党委副书记贾林教授介绍,...
阅读次数:2024-04-11 《羊城晚报》老广喝凉茶,幽门螺杆菌或更易根除!
《羊城晚报》老广喝凉茶,幽门螺杆菌或更易根除!
清热降火的凉茶是广东人居家旅行之标配。咽痛牙痛喝一杯、感冒发烧喝一杯……没有想到,喝凉茶对幽门螺杆菌(简称“Hp”)的根除也有用。4月10日,广州市第一人民医院(广州消化疾病中心)、广州市医学会、广州市医师协会、广州地区消化疾病质控中心联合发布了《广州幽门螺杆菌抗生素耐药监测报告及根除治疗建议(2024)》(以下简称《根治建议》)。《根治建议》指出,与其他城市不同,广州呈现幽门螺杆菌相对低耐药率的特点,患者幽门螺杆菌感染容易根除,...
阅读次数:2024-04-11 《新华社》“广东省肿瘤介入诊治联合重点实验室”在穗揭牌
《新华社》“广东省肿瘤介入诊治联合重点实验室”在穗揭牌
新华社客户端广州4月3日电(记者徐弘毅)“广东省肿瘤介入诊治联合重点实验室”3日在广州市第一人民医院揭牌,据称,将为推动肿瘤介入治疗的技术创新、临床应用以及相关科研成果转化提供基础,助力实现肿瘤疾病的早期诊断、精准治疗和有效预防。据医院方面介绍,该实验室是广东省大介入领域唯一获批的省重点实验室,实验室以肿瘤疾病诊疗的重大临床问题为导向,多学科医工交叉,融合前沿多组学、医学影像、纳米医学、3D类器官及人工智能等多学科新技术,...
阅读次数:2024-04-07做作业拖拉、“加餐”任务多、练乐器学画画……3月21日是世界睡眠日,中小学生的睡眠质量越来越引起关注。此前,广州市教育局发布《广州市提升学生体质健康水平行动实施方案(2021—2023年)》,要求保证小学生每天睡眠10小时,初中学生每天睡眠9小时,高中学生每天睡眠8小时,但家长们却认为这项要求“很难得到保证”。有哪些因素影响小学生的睡眠时间?在世界睡眠日即将到来之际,新快报记者进行了走访,并向专家咨询了学生睡眠建议。...
阅读次数:2024-03-26 《广州日报》广州公立医院首批!“港澳药械通”眼底病创新药落地广州市一南沙医院
《广州日报》广州公立医院首批!“港澳药械通”眼底病创新药落地广州市一南沙医院
罹患眼疾久治不愈,在家门口就可用上眼底创新药啦眼底病是眼科常见致盲疾病,其中糖尿病视网膜病变、视网膜中央静脉阻塞、黄斑变性、脉络膜新生血管最为常见。进口药物“布西珠单抗”是治疗眼底病的创新药,适用于治疗湿性年龄相关性黄斑变性和糖尿病黄斑水肿。记者获悉,广州市第一人民医院南沙医院是“港澳药械通”指定医疗机构,成为广州首家引进“布西珠单抗”的公立医院,已为多位有需求的患者注射了该药。52岁的唐先生,3年前右眼视力下降明显,...
阅读次数:2024-03-15 《南方日报》“港澳药械通”眼底创新药落地广州市一南沙医院
《南方日报》“港澳药械通”眼底创新药落地广州市一南沙医院
依托“港澳药械通”政策优势,广州市第一人民医院南沙医院(下称“广州市一南沙医院”)于2023年底成功引进治疗眼底病的进口药物“布西珠单抗”,成为广州首家引进该药物的公立医院。近期,多名眼底病患者在该医院完成注射治疗,从而改善了视力,实现长效疾病控制。唐先生治疗前影像检查3年前,52岁的唐先生(化名)右眼视力下降明显,同时伴有眼前黑影,视物变形。经过医院检查,被确诊患有糖尿病视网膜病变。此前,他已经进行了多次第一代抗VEGF(...
阅读次数:2024-03-15